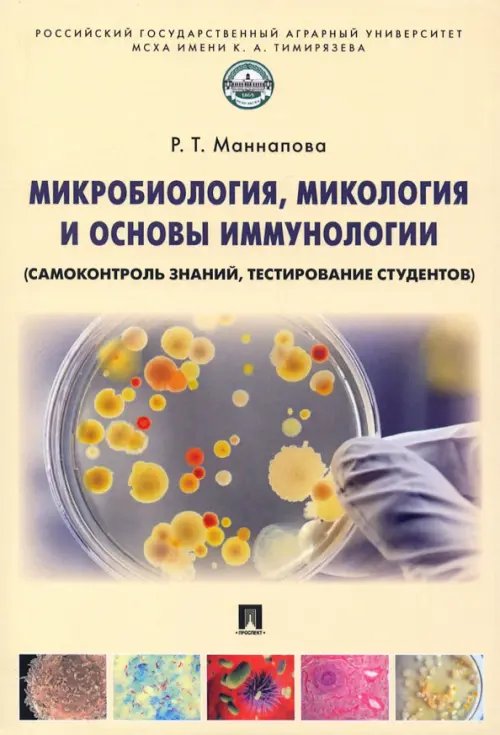
Микробиология, микология и основы иммунологии (самоконтроль знаний, тестирование студентов)

Аннотация: Микробиология, микология и основы иммунологии (самоконтроль знаний, тестирование студентов)
Учебное пособие является приложением к учебникам по направлениям подготовки 36.05.01 "Ветеринария" и 36.04.01/36.03.01 "Ветеринарно-санитарная экспертиза".
Оно предназначено для самоконтроля знаний студентами при подготовке к занятиям, коллоквиумам, зачетам, итоговому и интернет-контролю. Состоит из двух глав: тренажера для самоконтроля знаний по теоретическому материалу и тестового контроля для освоения материала лабораторно-практических занятий. Темы изложены по единому плану, что облегчает пользование учебным пособием, усвоение и прочное закрепление материала. В конце книги представлен терминологический словарь, а также сведения об основоположниках микробиологии и лауреатах Нобелевской премии по микробиологии и иммунологии.
| Автор/составитель | Маннапова Рамзия Тимергалеевна |
| Год выпуска | 2022 |
| ISBN | 978-5-392-36782-5 |
| Производитель | Проспект |
| Издательство | Проспект |
| Количество томов | 1 |
| Количество страниц | 360 |
| Переплет | Мягкая обложка |
| Размеры | 205x140x20 мм |
| Цвет | Жёлтый |
| Тип бумаги | офсетная (60-220 г/м2) |
| Вес | 420 |
| Язык | русский |